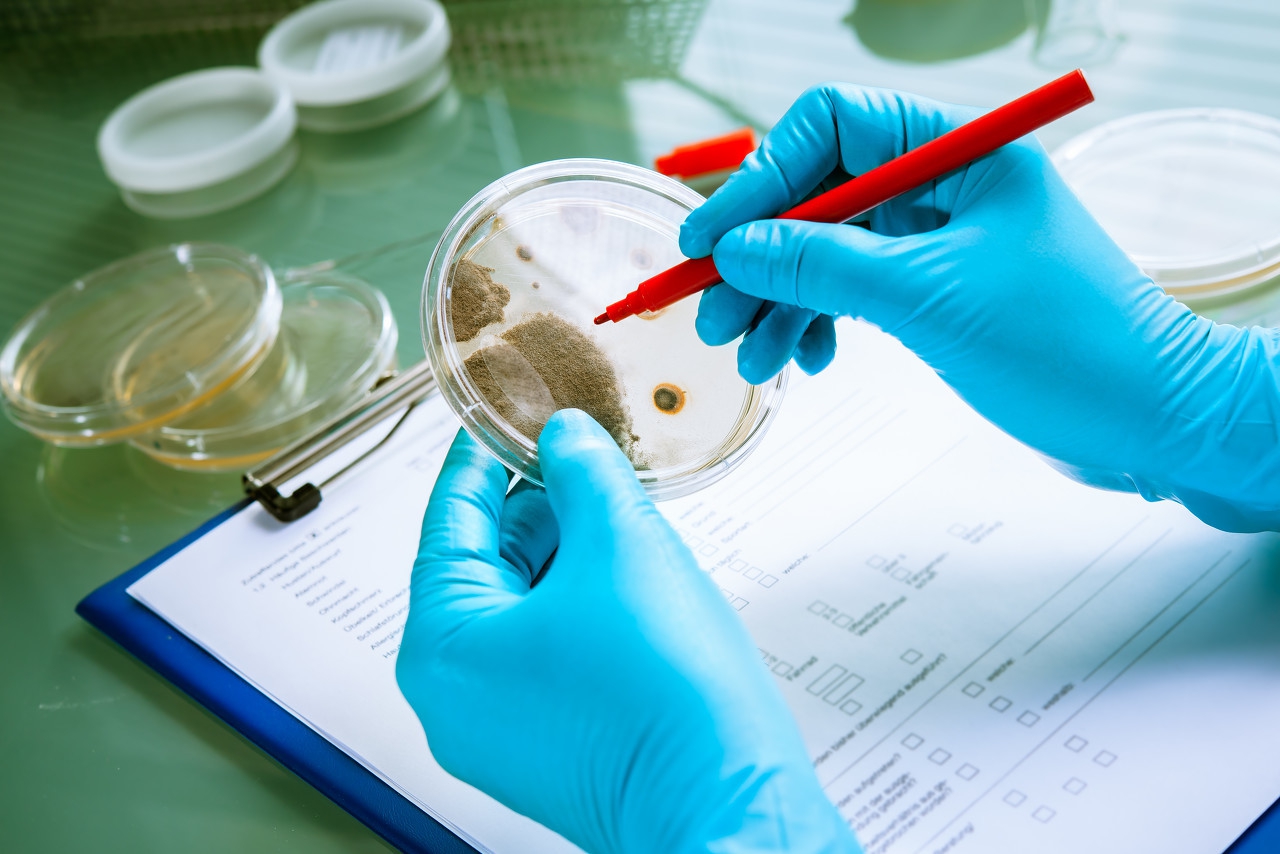
药师讲解用药,药师用药咨询问题和解析

吴文博 河北省石家庄市中医院
微生物是一类肉眼看不见或看不清的微小生物,由于个体微小,结构简单,通常要用光学显微镜和电子显微镜才能看清楚。微生物包括细菌、病毒、霉菌、酵母菌等。(但有些微生物是肉眼可以看见的,像属于真菌的蘑菇、灵芝等。根据存在的不同环境分为原核微生物、空间微生物、真菌微生物、酵母微生物、海洋微生物等。现代微生物学研究指出,生物界的微生物达几万种,大多数对人类有益,只有一少部分能致病。目前,在药物生产中广泛利用微生物来制备各类药物,如抗生素、维生素、氨基酸、及酶*制剂抑**、菌体产品、以及甾体激素的中间转化等。
微生物中药是指真菌类中药(如灵芝等)以及经微生物发酵之后而制成的中药(如神曲等)。中药是中华民族的瑰宝,早在千余年前,开始使用微生物(尽管还没有微生物这个概念),而且已开始将微生物发酵应用于中药炮制,成为世界上最早利用微生物对天然药物进行生物转化的国家之一。下面介绍几种微生物中药:
1.单味微生物中药
1.1植物类
(1)灵芝是以死亡倒木为生的木腐性真菌,其种类很多,中药学中的灵芝为:多孔菌科真菌赤芝或紫芝的干燥子实体。味甘,性平;归心、肺、肝、肾经。主治虚劳、咳嗽、气喘、失眠、消化不良,恶性肿瘤等。中药药理研究:灵芝对神经系统有抑制作用,对循环系统有降压和加强心脏收缩力的作用,对呼吸系统有祛痰作用,此外,还有护肝、提高免疫功能,抗菌等作用。
(2)猪苓(为多年生真菌):其子实体(猪苓花)是高级营养保健品。中药学的猪苓为多孔菌科真菌猪苓的干燥菌核。味甘、淡,性平;归肾、膀胱经。具有利水渗湿之功。治小便不利、水肿、泄泻、淋浊、带下。中药药理研究:具有利尿和抗菌作用。
(3)茯苓(为寄生在松树跟下的真菌):多孔菌科真菌茯苓的干燥菌核,多寄生于马尾松或赤松的根部。味甘、淡、性平;归心经、肺经、脾经、肾经,具有利水渗湿、益脾和胃、宁心安神之功用。中药药理研究:茯苓能增强机体免疫功能,茯苓多糖有明显的抗肿瘤及保肝脏作用。
(4)雷丸(多腐生于竹林的真菌):白蘑科真菌雷丸的干燥菌核。性微苦、味寒;归胃、大肠经。具有 杀虫消积之功。用于治疗绦虫、钩虫、蛔虫病,虫积腹痛,小儿疳积等。中药药理研究:雷丸有驱绦虫作用,对蛔虫、钩虫、阴道滴虫及囊虫也有杀灭作用。
另外还有马勃等。
1.2 动物类
(1)冬虫夏草:是一种特殊的虫和真菌共生的生物体。是冬虫夏草真菌的菌丝体通过各种方式感染蝙蝠蛾(鳞翅目蝙蝠蛾科蝙蝠蛾属昆虫)的幼虫,以其体内的有机物质作为营养能量来源进行寄生生活,经过不断生长发育和分化后,最终菌丝体扭结并形成子座伸出寄主外壳,从而形成的一种特殊的虫菌共生的生物体。其味甘、性温。归肾、肺经。具有养肺阴,补肾阳的功效,为平补阴阳之品,用于肺痨咳血,阳痿遗精等症。中药药理研究:有调节免疫系统功能、抗肿瘤、抗疲劳等多种功效。
(2)白僵蚕:为蚕蛾科昆虫蚕蛾的幼虫感染白僵菌而僵死的干燥全虫。 味辛咸,性平;归肝、肺经。具有祛风解痉,化痰散结之功。治中风失音、惊痫,头风,喉风;喉痹,瘰疬结核;丹毒,乳腺炎。中药药理研究:有抗惊厥和催眠作用。
2.复方微生物中药
传统的由发酵法炮制而得的中药,依据配料的不同可分为两大类:一类为药料与面粉混合发酵,如六神曲等;另一类为直接用药料进行发酵,如淡豆豉等。
2.1药料与面粉混合发酵
(1)神曲:我国制造神曲始于北魏,贾思勰在《齐民要术》中叙述了神曲的制法。神曲为辣蓼、青蒿、杏仁等药加入面粉或麸皮混合后,经发酵制成曲剂,含酵母菌、淀粉酶、复合维生素B等成分,有消食化积、健脾和胃等功效。神曲还可炮制加工成炒神曲、麸炒神曲、焦神曲。生神曲健脾开胃,并有发散作用;麸炒后以醒脾和胃为主,用于食积不化、脘腹胀满、不思饮食、肠鸣泄泻等;炒焦后消食化积力强,以治食积泄泻为主。
(2)建神曲:建神曲主产于福建泉州,为麦粉、麸皮、紫苏、荆芥、防风、厚朴、白术、木香、枳实、青皮等数十种药物经发酵*制专**而成。建曲性味苦微温,消食化积功效与神曲相似,并能理气化湿、健脾和中。
(3)半夏曲:半夏曲为半夏加面粉、姜汁等制成的曲剂。《本草纲目》中叙述了半夏曲的制法:“半夏研末,以姜汁、白矾汤和作饼,楮叶包置篮中,待生黄衣,晒干用,谓之半夏曲。”半夏曲有化痰湿,消食滞的功效。而未发酵的半夏则性味温辛,有毒,有燥湿化痰、降逆止呕、消痞散结等功效。
(4)采云曲:采云曲是以六曲为基础,再加桔梗、白术、紫苏、陈皮等二十多种药品加工制成的,性味作用与建曲相似,对于夏秋暑热伤中引起的食滞消化不良作用较好。
(5)沉香曲:沉香曲为沉香等多种药末和以神曲糊制成的曲剂。用沉香、木香、檀香、砂仁、蔻仁等20多种药材研成粉再加1/4的面粉,搅和压制而成。《饮片新参》称沉香曲有“理脾胃气,止痛泻,消胀满”的功用。
(6)红曲:红曲为曲霉科真菌红曲霉的菌丝体寄生在粳米上而成的红曲米,有健脾消食、活血化瘀的功效。《本草经疏》中称:“红曲,消食健脾胃与神曲相同,而活血和伤,惟红曲为能,故治血痢尤为要药。”李时珍在《本草纲目》中记述了红曲的制法:“红曲,本草不载,法出近世,亦奇术也。其法:白粳米……入曲母……其米……鲜红可爱。未过心者不甚佳。入药以陈久者良。”
2.2直接用药料进行发酵
(1)淡豆豉:淡豆豉为豆科植物大豆黑色的成熟种子经蒸罨发酵等加工而成,有解肌发表、宣郁除烦的功效。淡豆豉的制造历史悠久,在《伤寒论》中即有记载。《本草纲目》还详细叙述了其制作方法。《本草汇言》称:“淡豆豉,治天行时疾,疫疠瘟瘴之药也。”《药性论》载:“治时疾热病发汗;熬末,能止盗汗,除烦;生捣为丸服,治寒热风,胸中生疮;煮服,治血痢腹痛。”
(2)百药煎:百药煎为五倍子同茶叶等经发酵制成的块状物。李时珍在《本草纲目》中记述了百药煎的制法:“用五倍子为初末。每一斤,以真茶一两煎浓汁,入酵糟四两。擂烂拌和,器盛置糠缸中,待发起如发面状即成矣。捏作饼丸,晒干用。”百药煎有润肺化痰、止血止泻、解热生津的功效。《本草纲目》论述:“百药煎,功与五倍子不异。但经酿造,其体轻虚,其性浮收,且味带余甘,治上焦心肺、咳嗽痰饮、热渴诸病,含噙尤为相宜。”
(3)片仔癀:片仔癀由麝香、牛黄、蛇胆、三七等组成配方,其中的主要成分是中药三七的微生物发酵物。片仔癀具有清热解毒、消肿止痛的功效。片仔癀的配方及工艺至今秘而不宣,现已成为国家一级中药保护品种。
随着生物科技的发展,中药学与微生物学相结合,特别是通过发酵转化,能让中药发挥新的生机。比如借助真菌灵芝产生的丰富酶系通过对薏苡仁的转化,使薏苡仁的主要成分发生了变化。“康复灵”为抗癌验方,主要成分有灵芝发酵菌、*党**参、麦冬、猪苓、薏苡仁、淮山药等,经生物发酵转化后多数样品具有抑制小鼠/180肉瘤生长的作用。以上中药发酵成功的事例充分说明微生物发酵已成为中药现代化研究的重要内容之一。